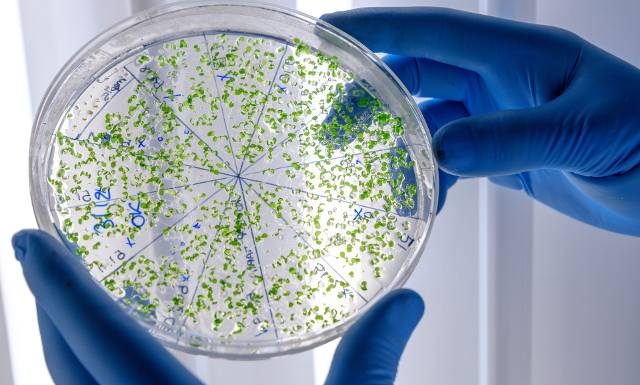
Więcej zachorowań i jeszcze więcej zgonów. Ta bakteria zabija i rozprzestrzenia się na kolejne kraje. WHO ostrzega: zagrożenie jest wysokie

W listopadzie 2024 roku w próbce ścieków komunalnych z Warszawy wykryto obecność wirusa polio typu 2. Państwowa Inspekcja Sanitarna rozszerzyła badania i wzmożyła nadzór nad przypadkami ostrych porażeń wiotkich. Przypomina też o konieczności szczepień przeciw poliomyelitis.
Źródło: klik
Właśnie kwitnie i można go spotkać praktycznie wszędzie: w lasach, parkach, na polach i łąkach. Uważany dawniej za pożyteczny i leczniczy obecnie wiadomo, że jest trujący i śmiertelnie niebezpieczny. Nasze babcie uznawały go za pomocny w leczeniu chorób wątroby...
Jesteśmy świadomi nieprawidłowości, które wynikały z uwarunkowań politycznych, konfliktów interesów, różnego rodzaju nacisków albo ogólnego pośpiechu przy rozstrzyganiu konkursów - mówi w wywiadzie dla Rynku Zdrowia prof. Wojciech Fendler, nowy prezes Agencji Badań Medycznych. Zapowiada wprowadzenie nowych mechanizmów dotyczących...
Powiązanie indywidualnej reakcji organizmu na witaminę D z immunokompetencją, czyli ogólnie mówiąc: wysoką odpornością – może stanowić klucz do wyjaśnienia mechanizmu, w jaki sposób witamina D chroni przed najpowszechniejszymi chorobami i jednocześnie sprzyja zdrowemu starzeniu się. Te zależności bada prof....
Czy możliwe jest wyłączenie ochrony zdrowia spod wpływu polityki i kto ma realną szansę skutecznie zmieniać system? Na te między innymi pytania odpowiedzą eksperci XXI Forum Rynku Zdrowia, które startuje dziś w Warszawie. Wydarzenie zainauguruje sesja z udziałem przedstawicieli kierownictwa czterech resortów i...
Nienawidzisz być na diecie? Nie musisz stosować jej codziennie, aby osiągnąć świetne efekty odchudzania! Ta metoda jest przebadana i wyjątkowo skuteczna, ma też wiele wersji. Dzięki temu jeszcze łatwiej wprowadzisz ją w życie i spalisz tkankę tłuszczową nie robiąc...
Kupa jest ważna – nie wstydźmy się tego! I choć może się to wydawać błahe, to kał (lub jego brak) może wpłynąć na nasz cały dzień (a nawet tydzień!). Zaparcia czy problemy z oddaniem stolca to nic przyjemnego. Jak...
Kapcie, papucie, laczki – niezależnie od tego, jak na nie mówimy, to najpopularniejsze obuwie, jakie nakładamy na nasze stopy w domu. Niektórzy wybierają po prostu buty, inni zaś chodzą po swoim domu boso. A co rekomendują eksperci? Zobacz, w...
Liczba zgonów rośnie dużo szybciej niż zachorowań – podkreślił dr Philippe Barboza z WHO. W niektórych krajach wzrosła aż o 125 proc. Bakteria przecinkowca wywołuje ostrą i zakaźną chorobę przewodu pokarmowego jaką jest cholera. Jest ona uleczalna, jednak zachorowalność...
Przed nami, na czerwcowym niebie spektakularne zjawisko – Truskawkowa Pełnia Księżyca, która rozpocznie się już niebawem. W tym miesiącu zbiega się ona z przesileniem. Czy może wpłynąć na nasze samopoczucie? Ludzie od wieków doszukiwali się związku między ziemskim satelitą...